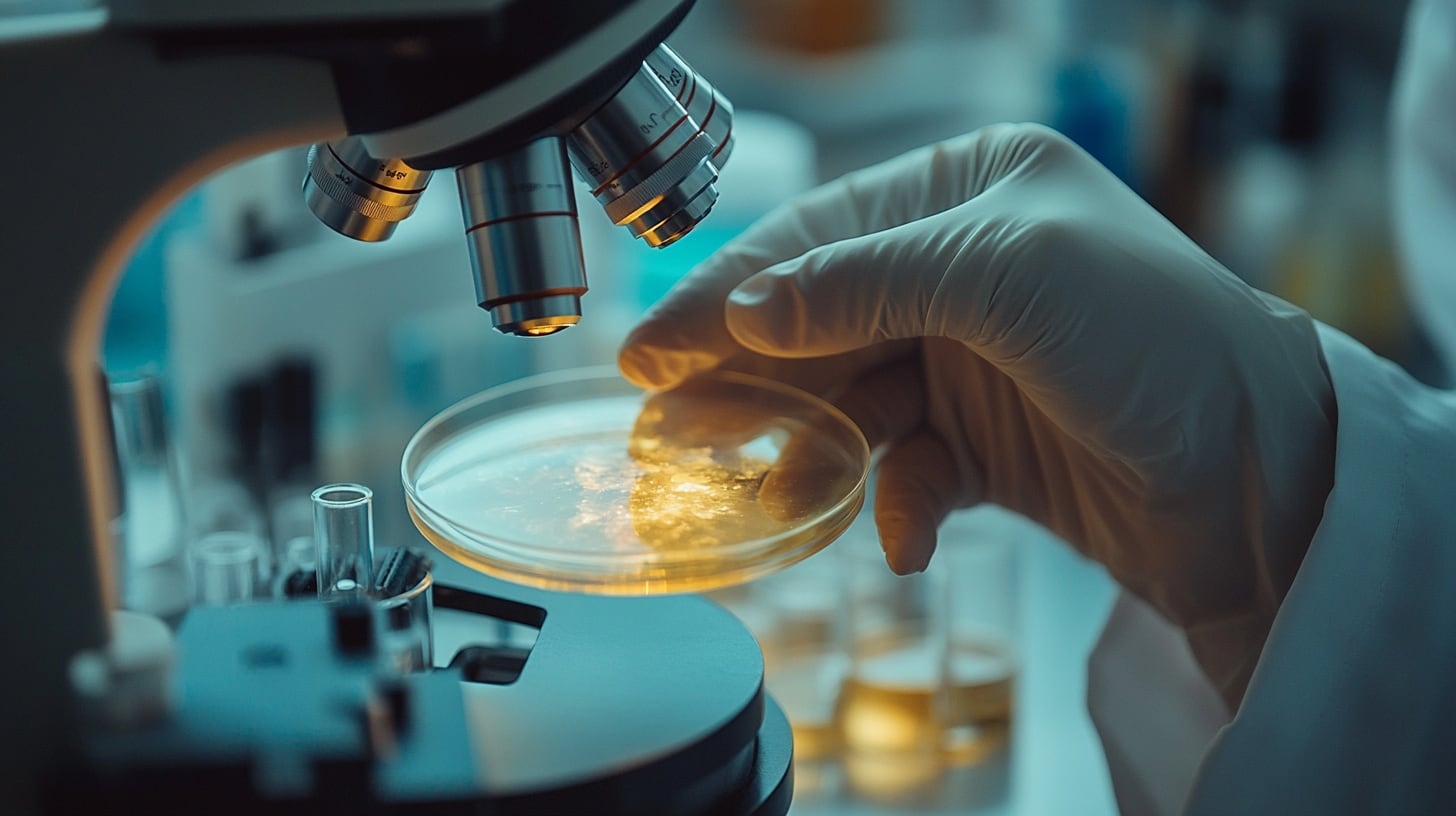

La exposición a metales puede empeorar las enfermedades cardíacas, según expertos

(Ernie Mundell – HealthDay News) – Cadmio, uranio y cobalto: estos y otros metales que se encuentran en el ambiente pueden acumularse en el cuerpo y exacerbar la enfermedad cardiaca, sugiere una investigación reciente. ”Nuestros hallazgos resaltan la importancia de considerar la exposición a los metales como un factor de riesgo significativo para la aterosclerosis y la enfermedad cardiovascular”, señaló la autora principal del estudio, Katlyn McGraw, científica investigadora postdoctoral de la Universidad de Columbia, en la ciudad de Nueva York.
“Esto podría conducir a nuevas estrategias de prevención y tratamiento que se dirijan a la exposición a los metales”, añadió en un comunicado de prensa de la Columbia. El equipo de McGraw encontró que a medida que aumentaban los niveles de varios metales en las muestras de orina de las personas, también lo hacían las evidencias de arterias más rígidas y calcificadas, un componente clave de la enfermedad cardiaca.
La investigación aparece en la edición del 18 de septiembre de la revista Journal of the American College of Cardiology. El equipo de Columbia observó específicamente un proceso llamado aterosclerosis, el endurecimiento gradual de los vasos sanguíneos causado por la acumulación de placas de grasa. La aterosclerosis también puede provocar la acumulación de depósitos de calcio poco saludables en las arterias.

¿La exposición a metales tóxicos ambientales contribuye a todo esto?
Para averiguarlo, el equipo de McGraw revisó una importante base de datos de más de 6,400 adultos estadounidenses de mediana edad y mayores que estaban libres de enfermedad cardiaca cuando se unieron al estudio entre 2000 y 2002. Las muestras de orina rastrearon los niveles de seis metales ambientales de cada participante que ya se sabía que tenían vínculos con la enfermedad cardíaca: cadmio, cobalto, cobre, tungsteno, uranio y zinc.
Las personas suelen estar expuestas al cadmio a través del humo del tabaco, mientras que los otros cinco metales están relacionados con los fertilizantes agrícolas, las baterías, la producción de petróleo, la soldadura, la minería y la producción de energía nuclear. Los investigadores dividieron a los participantes en cuatro grupos, que iban de las concentraciones más bajas a las más altas de los diversos metales en la orina.
En el caso del cadmio, las personas que se ubicaron en el cuarto más alto tenían niveles de calcificación arterial que fueron un 75 por ciento más altos durante el período de estudio de 10 años, en comparación con los del cuartil más bajo. En el caso del tungsteno, el uranio y el cobalto en la orina, esas cifras fueron un 45%, un 39% y un 47% más altas, respectivamente.
Las personas con los niveles urinarios más altos de cobre y zinc tenían niveles de calcificación que eran un 33% y un 57% más altos, respectivamente, que aquellos con los niveles más bajos. También hubo puntos geográficos de puntos críticos para niveles especialmente altos de metales en la orina. Por ejemplo, las personas que vivían en Los Ángeles tenían niveles urinarios de tungsteno y uranio marcadamente más altos, y niveles algo más altos de cadmio, cobalto y cobre, mostró la investigación.
McGraw cree que los hallazgos deberían servir como una llamada de atención para los responsables políticos preocupados por el medio ambiente. ”La contaminación es el mayor riesgo ambiental para la salud cardiovascular”, dijo. “Dada la presencia generalizada de estos metales debido a las actividades industriales y agrícolas, este estudio requiere una mayor conciencia y medidas regulatorias para limitar la exposición y proteger la salud cardiovascular”.
Más información
Para obtener más información sobre la aterosclerosis, diríjase a la Asociación Americana del Corazón.
FUENTE: Universidad de Columbia, comunicado de prensa, 18 de septiembre de 2024
* Ernie Mundell. HealthDay Reporters ©The New York Times 2024




